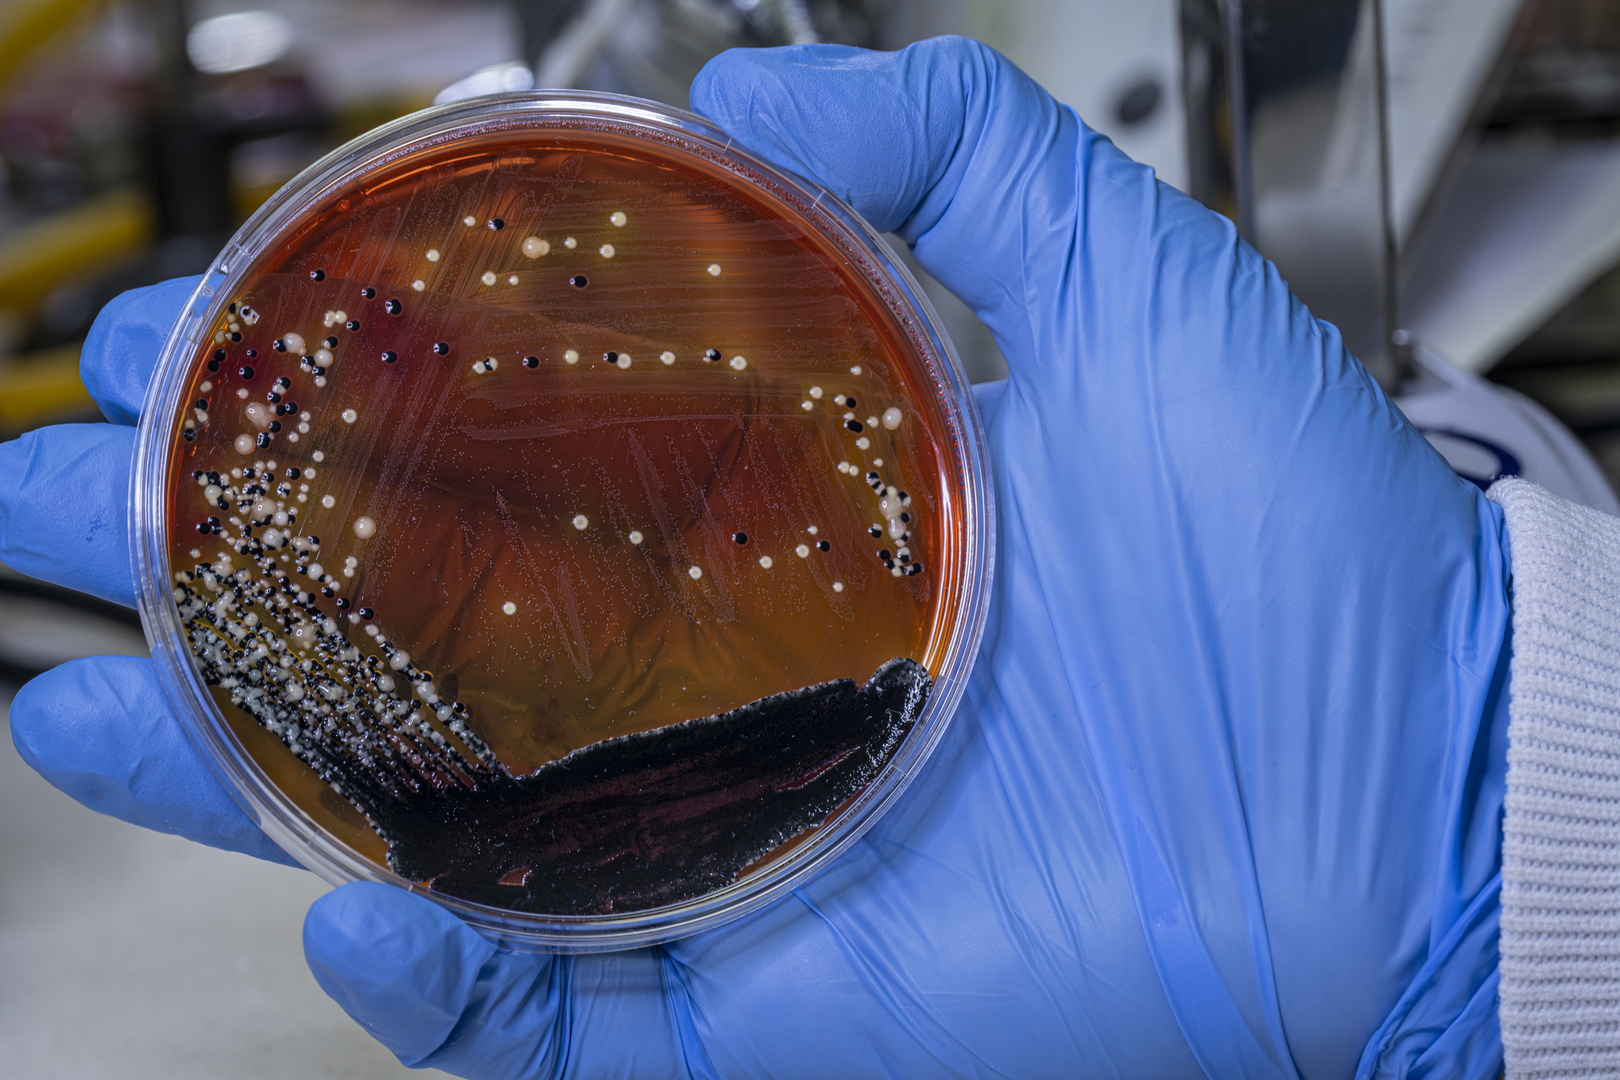

بكتيريا بشرية تتحدى الفضاء الخارجي وتنجو في أقسى الظروف!

كشفت دراسة علمية حديثة أن بكتيريا الأمعاء البشرية الضرورية لصحة الإنسان تمتلك قدرة مذهلة على تحمل ظروف رحلات الفضاء القاسية....
Redirecting to full article...
كشفت دراسة علمية حديثة أن بكتيريا الأمعاء البشرية الضرورية لصحة الإنسان تمتلك قدرة مذهلة على تحمل ظروف رحلات الفضاء القاسية....
Redirecting to full article...